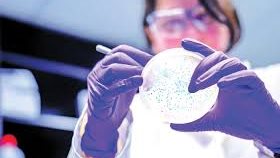

تسبب الموت للحوامل، مضاعفات السالمونيلا ونصائح للحماية منها
يمكن أن تسبب بكتيريا السالمونيلا التهاب المعدة والأمعاء، وحمى التيفويد، وغيرها من الالتهابات، وتشمل الأعراض الشائعة لعدوى السالمونيلا الإسهال وتشنجات البطن والحمى والقيء.
وتوجد أنواع عديدة من بكتيريا السالمونيلا، ويعاني معظم الأشخاص المصابين بها من أعراض خفيفة ويتعافون دون علاج ومع ذلك، يحتاج البعض إلى الرعاية في المستشفى.
غالبًا ما يصاب الأشخاص بهذا النوع من العدوى بعد ملامسة الطعام أو الماء الملوث.

ويوجد أكثر من 2500 نوع فرعي من مصدر موثوق به بما في ذلك السلالات الحيوانية والبشرية، وبعضها موجود في الحيوانات ولكن يمكن أن يؤثر أيضًا على البشر من المحتمل أن يصيب الأشخاص أقل من 100 سلالة من بكتيريا السالمونيلا.
أعراض عدوى السالمونيلا
تظهر الأعراض عادةً بين 6 ساعات و6 أيام بعد الإصابة الأولية وتستمر من 4 إلى 7 أيام، وفقًا لموقع "Medical news today" الطبي.
وتشمل الأعراض:
الإسهال
التشنجات في المعدة وآلام في البطن
حمى مفاجئة
غثيان
القيء، في بعض الحالات
ويمكن لبعض سلالات السالمونيلا أن تصيب البول والدم والعظام والمفاصل والجهاز العصبي، بما في ذلك السائل الشوكي والدماغ، ويمكن أن تنتج مضاعفات خطيرة.
يعاني بعض الأشخاص المصابين بعدوى السالمونيلا من آلام المفاصل المعروفة باسم التهاب المفاصل التفاعلي، ويمكن أن يستمر لعدة أشهر أو سنوات أو أن يصبح التهابًا مزمنًا في المفاصل.
تعيش بكتيريا السالمونيلا في أمعاء الطيور والحيوانات والبشر، وتتطور معظم حالات العدوى لدى البشر بعد تناول الطعام أو شرب الماء الملوث.
اللحوم غير المطبوخة، والمأكولات البحرية، والدواجن
ويمكن أن يحدث التلوث أثناء المعالجة على سبيل المثال، يعد صيد المأكولات البحرية في المياه الملوثة سببًا شائعًا لعدوى السالمونيلا.
كما يمكن أن تنتشر العدوى إذا تعامل الشخص مع اللحوم النيئة الملوثة، ثم لمس الأطعمة الأخرى دون غسل يديه.
البيض غير المطبوخ
ويمكن أن يحتوي بيض الطيور المصابة بعدوى السالمونيلا على البكتيريا.
طهي البيض يمكن أن يقلل من المخاطر ومع ذلك، فإن بعض الصلصات الشعبية مثل المايونيز يمكن أن تحتوي على البيض النيئ.
الفواكه وخضراوات
يمكن أن يؤدي سقي نباتات الفاكهة أو الخضروات بالمياه الملوثة أو غسل المنتجات بهذه المياه إلى الإصابة بالسالمونيلا.
قلة النظافة
يمكن أن يحدث التلوث والعدوى إذا لم يحافظ الأشخاص على نظافة أسطح المطبخ ولم يغسلوا أيديهم أثناء إعداد الطعام وبعد استخدام الحمام وبعد تغيير حفاضات الطفل.
وعندما تكون البكتيريا على أيدي الشخص ويمكنه نشرها عن طريق لمس أشخاص آخرين أو عن طريق لمس الأشياء والأسطح المستخدمة بشكل متكرر.
الزواحف أو البرمائيات الأليفة
وتحمل معظم الزواحف والبرمائيات السالمونيلا في أحشائها دون أن تصاب بالمرض، لقد ألقوا البكتيريا في فضلاتهم.
ويمكن بعد ذلك أن تنتشر البكتيريا بسرعة إلى جلدهم وأي شيء يتلامسون معه، بما في ذلك الأقفاص والألعاب والملابس والأثاث والأسطح المنزلية.
ولا ينبغي الاحتفاظ بالزواحف الأليفة في الداخل إذا كان هناك أطفال أقل من 5 سنوات أو نساء حوامل أو كبار السن أو أشخاص يعانون من ضعف في جهاز المناعة في الأسرة.
عوامل الخطر للإصابة بالسالمونيلا
تعد عدوى السالمونيلا أكثر شيوعًا في الصيف منها في الشتاء.
وبشكل عام، الأشخاص الأكثر عرضة لخطر الإصابة بالعدوى هم:
الأطفال
كبار السن
الأشخاص الذين يعانون من ضعف في جهاز المناعة
النساء الحوامل
بسبب خطر العدوى، يجب على مقدمي الرعاية عدم السماح للأطفال الصغار بالتعامل مع الزواحف أو الكتاكيت والطيور الصغيرة.
إذا أصيبت امرأة بعدوى السالمونيلا أثناء الحمل فقد تكون هناك مخاطر إضافية، ويمكن أن يؤدي الجفاف ونقص العناصر الغذائية الناتجة عن العدوى إلى الإضرار بالأم والطفل.
وفي حوالي 4% من عدوى السالمونيلا أثناء الحمل تنتشر البكتيريا إلى الدم، وهذا يمكن أن يؤدي إلى الإنتان داخل الرحم وهي حالة قد تهدد الحياة.
علاج السالمونيلا
وعادةً ما تختفي أعراض التهاب المعدة والأمعاء الناجم عن السالمونيلا دون علاج بعد 4 إلى 7 أيام.
وقد تشمل العلاجات ما يلي:
السوائل لمنع الجفاف.
الأدوية المضادة للحركة لتقليل التشنج ووقف الإسهال
المضادات الحيوية للأعراض الشديدة أو إذا دخلت البكتيريا إلى مجرى الدم أو من المحتمل أن تفعل ذلك.
لن يصف الطبيب دائمًا المضادات الحيوية للسالمونيلا، حيث كشفت الأبحاث أن الإفراط في الاستخدام يمكن أن يؤدي إلى مقاومة المضادات الحيوية، وهذا يزيد من خطر ظهور العدوى مرة أخرى.
الوقاية من عدوى السالمونيلا
تعد النظافة الجيدة أمرًا أساسيًا للوقاية من عدوى السالمونيلا، هنا بعض النصائح:
غسل اليدين
يجب على الأشخاص غسل أيديهم بانتظام بالصابون والماء الدافئ أو استخدام معقم اليدين، وهذا مهم بشكل خاص:
قبل إعداد أو تناول الطعام
بعد استخدام الحمام
بعد تغيير حفاضات الطفل
بعد لمس الحيوانات الأليفة والحيوانات الأخرى
تسليم طعام
عند التعامل مع الطعام:
الفصل بين الأطعمة المطبوخة والأطعمة النيئة.
تخزين الأطعمة النيئة في الثلاجة على الرفوف الموجودة أسفل الأطعمة الجاهزة للأكل.
غسل الفواكه والخضروات النيئة جيدًا قبل تناولها.
طهي الأطعمة جيدًا، وخاصة اللحوم والبيض.
الحفاظ على نظافة أدوات الطبخ وأسطح العمل.
استبدل فوط الأطباق المستعملة بأخرى نظيفة بانتظام.
تجنب شرب المياه غير المعالجة، على سبيل المثال، من الجداول والأنهار والبحيرات.
يمكن أن تعيش السالمونيلا لفترات زمنية متفاوتة في الأطعمة المختلفة، فوجد الباحثون أن البكتيريا يمكن أن تعيش في الوجبات الخفيفة من البسكويت والمكسرات لمدة 6 أشهر على الأقل.
ونقدم لكم من خلال موقع (فيتو)، تغطية ورصدًا مستمرًّا على مدار الـ 24 ساعة لـ أسعار الذهب، أسعار اللحوم ، أسعار الدولار ، أسعار اليورو ، أسعار العملات ، أخبار الرياضة ، أخبار مصر، أخبار اقتصاد ، أخبار المحافظات ، أخبار السياسة، أخبار الحوادث ، ويقوم فريقنا بمتابعة حصرية لجميع الدوريات العالمية مثل الدوري الإنجليزي ، الدوري الإيطالي ، الدوري المصري، دوري أبطال أوروبا ، دوري أبطال أفريقيا ، دوري أبطال آسيا ، والأحداث الهامة و السياسة الخارجية والداخلية بالإضافة للنقل الحصري لـ أخبار الفن والعديد من الأنشطة الثقافية والأدبية.
